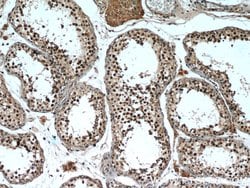
TCF4 Rabbit anti-Human, Mouse, Polyclonal, Proteintech:Antibodies:Primary

missing translation for 'onlineSavingsMsg'
Learn More
Learn More
TCF4 Rabbit anti-Human, Mouse, Polyclonal, Proteintech
Rabbit Polyclonal Antibody
145.00€ - 410.00€
Specifica
| Antigene | TCF4 |
|---|---|
| Concentrazione | 0.21 mg/mL |
| Applicazioni | Immunohistochemistry (Paraffin), Immunoprecipitation, Western Blot |
| Classificazione | Polyclonal |
| Coniugato | Unconjugated |
| Codice del prodotto | Marca | Quantità | Prezzo | Quantità e disponibilità | |||||
|---|---|---|---|---|---|---|---|---|---|
| Codice del prodotto | Marca | Quantità | Prezzo | Quantità e disponibilità | |||||
|
16811875
|
Proteintech
22337-1-AP-20UL |
20 μL |
145.00€
20µL |
Effettua il login per acquistare questo articolo Hai bisogno di un conto web ? Registrati oggi stesso! | |||||
|
16801875
|
Proteintech
22337-1-AP-150UL |
150 μL |
410.00€
150µL |
Effettua il login per acquistare questo articolo Hai bisogno di un conto web ? Registrati oggi stesso! | |||||
Descrizione
TCF4 is transcription factor 4, a basic helix-turn-helix transcription factor. The encoded protein recognizes an Ephrussi-box (′E-box′) binding site (′CANNTG′) - a motif first identified in immunoglobulin enhancers. This gene is expressed predomitly in pre-B-cells, although it is found in other tissues as well. Defects in this gene are a cause of Pitt-Hopkins syndrome.Specifica
| TCF4 | |
| Immunohistochemistry (Paraffin), Immunoprecipitation, Western Blot | |
| Unconjugated | |
| Rabbit | |
| Mouse, Human | |
| P15884, Q60722 | |
| 21413, 6925 | |
| TCF4 Fusion Protein Ag17813 | |
| Primary | |
| -20°C | |
| TCF4 |
| 0.21 mg/mL | |
| Polyclonal | |
| Liquid | |
| RUO | |
| PBS with 50% glycerol and 0.02% sodium azide; pH 7.3 | |
| bHLHb19, E2 2, ITF 2, ITF2, PTHS, SEF 2, SEF2, SEF2 1, SEF2 1A, SEF2 1B, SL3 3 enhancer factor 2, TCF 4, TCF4, transcription factor 4 | |
| TCF4 | |
| IgG | |
| Antigen Affinity Chromatography | |
| Antibody |
Individuate un'opportunità di miglioramento?Condividi una correzione di contenuto
Correzione del contenuto del prodotto
Fornite il vostro feedback sul contenuto del prodotto compilando il modulo sottostante.
Titolo del prodotto